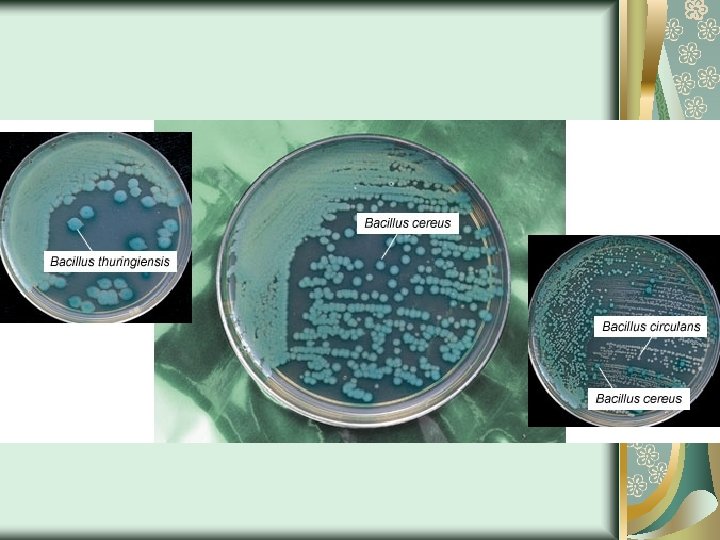

STERILISASI MEDIA NUTRISI Oleh Dr Hadi Ismono dr

























































- Slides: 57

STERILISASI MEDIA NUTRISI Oleh : Dr. Hadi Ismono. , dr. , M. Kes

Methode Sterilisasi Pemanasan Basah Autoclaf Dgn Bacterisida Methode Sterilisasi Pemanasan Kering Oven Flaming Air Mendidih Gelombang Pendek

Pengertian Steril Bebas dari segala macam bentuk kehidupan Sterilisasi Membebaskan tiap benda/substansi dr semua kehidupan dlm bentuk apapun. Desinfeksi Mematikan / menyingkirkan mikroorganisme yang dpt menyebabkan infeksi

Next… Fungsi Untuk mengisolasi mikroorganisme dan mendapatkan biakan murni Praktek Alat, bahan, media, dll.

FAKTOR-FAKTOR YANG MEMPENGARUHI STERILISASI DAN DESINFEKSI 1. Hidrasi (Pengurangan cairan dalam tubuh) Hidrasi berperan dalam proses denaturasi & koagulasi oleh panas (kalor). Koagulasi berlangsung baik bila protein pd bakteri cukup mengandung air.

2. Pengaruh Suhu Semakin rendah suhu yg digunakan semakin lama waktu yg diperlukan utk membunuh mikroorganisme Sifat mikrobisida dr bahan kimia pd umumnya mjd makin efektif bila dibuat semakin hangat

3. Konsentrasi tidak boleh terlalu pekat Bila konsentrasi disinfektan melampaui konsentrasi (misal >1% pd fenol), maka peningkatan daya disinfeksi semakin berkurang

4. Oligodinamika Mrpk aktivitas yg diperlihatkan logam berat dlm jmlh yg sangat sedikit dimana dapat menghambat pertumbuhan mikroorganisme di sekitar logam tsb

5. Disinfektan Keefektifan disinfektan, memp sifat al : ü Memp sifat mikrobisida yg sempurna dlm waktu beberapa menit, paling lama 1 jam ü Tidak merusak bahan ü Tidak hilang keaktifannya oleh bahan dr luar ü Stabil dlm penyimpanan ü Mudah didapat dan tdk mahal

Cara-cara Sterilisasi FISIK Pemanasan Sinar gelombang pendek (radiasi) Sinar-X, Sinar UV, Sinar Gamma KIMIA Menggunakan Bahan kimia MEKANIK Saringan / filter

Metode sterilisasi Ada 2 cara sterilisasi : 1. Pemanasan basah : digunakan pada kebanyakan media perbenihan karena mengandung air 2. Pemanasan kering : digunkan untuk alat-alat dari gelas, alat-alat dari metal, kertas pembungkus barang yg tidak mengkerut oleh panas, minyak, waxes dan powder

Metode sterilisasi a. Pemanasan Basah Prinsipnya adalah dengan cara mengkoagulasi atau denaturasi protein penyusun tubuh mikroba sehingga dapat membunuh mikroba.

Uap bertekanan (autoklaf) ü Digunakan untuk sterilisasi alat gelas ü Waktu yang dibutuhkan untuk sterilisasi larutan suhu 121ºC ü Uap jenuh ini dapat menghancurkan spora bakteri yang tahan pemanasan.

Autoclav Tekanan uap air Temperatur Waktu sterilisasi 0 1000 C - 10 1150 C 45 menit 15 1210 C 18 menit 30 1340 C 3 menit

Autoklav

Pemanasan dengan bakterisida ü Digunakan untuk sterilisasi larutan berair atau suspensi obat yang tidak stabil dalam autoklaf. ü Larutan yang ditambahkan bakterisida dipanaskan pada suhu 100ºC selama 10 menit di dalam pemanas air ü Bakterisida yang digunakan 0, 5% fenol; 0, 5% klorobutanol; 0, 002 % fenil merkuri nitrat; 0, 2% klorokresol.

Metode Sterilisasi b. Pemanasan Kering Prinsipnya adalah protein mikroba pertama-tama akan mengalami dehidrasi sampai kering. Selanjutnya teroksidasi oleh oksigen dari udara sehingga menyebabkan mikrobanya mati.

Udara panas oven ü Digunakan untuk sterilisasi alat gelas (tabung reaksi, petri, pipet), alat bedah (gunting, kapas alat suntik) ü Suhu sterilisasi yang digunakan adalah 170ºC selama 1 jam, 160ºC selama 2 jam, 150ºC selama 3 jam.

Flaming ü Dengan jilatan api thd jarum, mulut tabung biakan, kaca objek, kaca penutup ü Benda 2 tsb dijilatkan pd api bunsen tanpa membiarkannya memijar Bunsen

Air mendidih ü Digunakan untuk sterilisasi alat bedah seperti jarum. ü Hanya dilakukan dalam keadaan darurat. ü Dapat membunuh bentuk vegetatif mikroorganisme tetapi tidak sporanya.

Sterilisasi gelombang pendek Sterilisasi dengan radiasi Menggunakan : Udara panas : Oven, 170 -180 derajat C, selama 2 jam Uap panas : Otoklaf, 121 derajad C, 1 -2 Atm. , 1530 Menit. ü Prinsipnya Radiasi menembus dinding sel dengan langsung mengenai DNA dari inti sel sehingga mikroba mengalami mutasi. ü Digunakan untuk sterilisasi bahan atau produk yang peka terhadap panas ü Ada dua macam radiasi yang digunakan : gelombang elektromagnetik (sinar x, sinar γ) dan arus partikel kecil (sinar α dan β).

INDIKATOR STERILISASI • Ada 2 cara yg biasa digunakan : a. Indikator kimia b. Indikator spora a. Indikator kimia • Diletakkan di tengah dari bahan yang hendak di disterilkan (bagian yang paling dingin), mis : bag paling bawah dari chamber 1. Browne’s sterilizer controlo tube ü Berisi satu larutan yg berwarna merah berubah menjadi hijau bila dipanasi ü Bahan ini harus disimpan di bawah 200 C Mencegah perubahan warna prematur ü Digunakan secara rutin

2. Adhesive tape (Bowie Disk Autoclav tape test) Untuk mengetahui/mengukur penetrasi dari uap air bersama-sama dengan tes lain b. Indikator Spora ü Spora bakteri kering diletakkan diantara bahan yang disteril dan setelah proses tsb diperiksa viabilitasnya ü Bacillus stearothermophilus satu termophilic bacteria dpt tumbuh pd suhu 55 – 600 C yg dipakai sbg tes ü Sporanya dapat dirusak pada suhu 1210 C pada 12 menit

Sterilisasi KIMIA Desinfektan Desinfeksi adalah membunuh mikroorganisme penyebab penyakit dengan disinfektan (antiseptik) Ada 2 istilah : Desinfektan dan Antiseptik

Macam-macam desinfektan yang digunakan: 1. Alkohol ü Etil alkohol atau propil alkohol digunakan untuk mendesinfeksi kulit. ü Alkohol yang dicampur dengan aldehid digunakan dalam bidang kedokteran gigi untuk mendesinfeksi permukaan

2. Aldehid ü Glutaraldehid merupakan salah satu desinfektan yang populer pada kedokteran gigi ü Glutaraldehid 2% dapat dipakai untuk mendesinfeksi alat-alat yang tidak dapat disterilkan ü Larutan glutaraldehid 2% efektif terhadap bakteri vegetatif seperti M. tuberculosis, fungi, dan virus tidak akan mati dalam waktu 10 -20 menit, sedang spora baru akan mati setelah 10 jam.

3. Biguanid ü Zat ini sangat aktif terhadap bakteri Gram(+) maupun Gram (-) ü Contoh : Klorheksidin

4. Senyawa halogen. ü Hipoklorit dan povidon-iodin adalah zat oksidasi dan melepaskan ion halide.

5. Fenol ü Larutan jernih, tidak mengiritasi kulit dan dapat digunakan untuk membersihkan alat yang terkontaminasi. ü Sebagian besar bakteri dapat dibunuh oleh zat ini ü Banyak digunakan di rumah sakit dan laboratorium.

6. Klorsilenol ü Klorsilenol merupakan larutan yang tidak mengiritasi dan banyak digunakan sebagai antiseptik ü Aktifitasnya rendah terhadap banyak bakteri dan penggunaannya terbatas sebagai desinfektan (misalnya Dettol).

7. Iodophor ü Untuk mendesinfeksi permukaan ü Zat ini harus dilarutkan baru setiap hari dengan akuades. ü Dalam bentuk larutan, desinfektan ini tetap efektif namun kurang efektif bagi kain atau bahan plastik.

Teknik Aseptik Segala tindakan / pekerjaan harus mempertimbangkan sterilitas

Laminar flow



Sterilisasi MEKANIK Digunakan bahan rusak pemanasan Filter : Macam-macam filter yang dipakai : 1. Berkefeld, Chamberland filter 2. Soltz filter dari asbes 3. Glass filter 4. Cellulose membrane filter

MEDIA Ialah bahan untuk menumbuhkan mikroba Macam : Padat, ditambah pemadat Cair, tidak ditambah pemadat Semi Padat, 50% pemadat Susunan : Air, Nitrogen, Karbon, dan faktor pertumbuhan

MEDIA PEMBIAKAN MIKROBIOLOGI Ose (lup inokulasi) merupakan alat dasar dalam praktikum mikrobiologi yang terbuat dari bahan tertentu seperti kawat platina, namun yang lebih umum digunakan di laboratorium pengajaran dan lebih murah harganya ialah kawat nikrom (nichrome) dengan diameter lingkaran pada ujung lup berkisar antara 2 sampai 4 mm. Ose LUP INOKULASI

Mikroorganisme dibiakkan di laboratorium pada medium yang terdiri dari bahan nutrient. Biasanya pemilihan medium yang dipakai bergantung kepada banyak faktor, seperti apa jenis mikroorganisme yang akan dibiakkan. Pembiakan untuk pertumbuhan bakteri agar dapat tetap dipertahankan harus mengandung semua zat makanan suasana yang diperlukan oleh organisme tersebut. Faktor lain seperti PH, suhu, dan pendinginan harus dikendalikan dengan baik.

Tipe media pembiakan berdasarkan bentuk dan konsistensinya : ü Media Padat : Yaitu media berbentuk padat yang mengandung agar 1 -1, 5%, contoh : Nutrient agar dan Blood Agar NUTRIENT AGAR BLOOD AGAR

ü Media Cair : Yaitu media berbentuk cair yang tidak mengandung agar, contoh : Nutrient Broth ü Media Semi Padat (semisolid) : Yaitu media yang berbentuk padat pada suhu dingin, dan berbentuk cir bila suhu panas, contoh : Sulfid Indol Motility (SIM)

q Berdasarkan kegunaannya : ü Media Umum : Digunakan secara umum dimana media ini dapat ditumbuhi oleh berbagai jenis mikroorganisme baik jamur maupun bakteri. Contoh : Media dalam Erlenmeyer

Media Selektif : Media ini dipakai untuk menyeleksi mikrorganisme sesuai dengan yang diinginkan, jadi hanya satu jenis mikrorganisme saja yang dapat tumbuh dalam media ini atau hanya satu kelompok tertentu saja, misalnya media Salmonella atau Sigella dari makanan atau bahan lain. Contoh : Manitol Salt Agar (MSA)

ü Media Diferensial : Media ini dipergunakan untuk menyeleksi mikrorganisme dimana dapat ditumbuhi berbagai jenis mikrorganisme tapi salah satu diantaranya dapat memberikan ciri yang khas sehingga dapat dibedakan dari yang lain dapat dipisahkan. Contoh : Mc. Conkey Agar

ü Media Enrichment : Medium ini gunanya untuk menumbuhkan mikrorganisme untuk keperluan tertentu. Dibiakkan dalam medium ini supaya sel-sel mikrorganisme tersebut dapat berkembang dengan cepat sehingga diperoleh populasi yang tinggi. Kompossisi medium sangat diperlukan dan sangat menguntungkan bagi pertumbuhan sel mikrorganisme yang bersangkutan. Contoh : Selenit-F Broth

NUTRISI Adalah merupakan bahan makanan mikroba Terbagi menjadi 2, yaitu : 1) Katabolisme adalah suatu peristiwa perubahan senyawa kompleks menjadi senyawa yg lebih sederhana. 2) Anabolisme (Sintaksis) adalah suatu peristiwa perubahan senyawa sederhana menjadi senyawa yg lebih kompleks.

Bentuk Nutrisi : Padat, mikroba holozoik : Suatu mikroorganisme yg mengambil makanan nya dari mikroorganisme lain seperti bakteri atau gang (alga) ex : Halobacterium tipe holozoik 2. Cair, Mikroba holofitik : Cara bakteri menghasilkan makanan dg cara melakukan fotosintesis disebut jg organsme Autotrof (bakteri yg dapat menghasilkan makanan sendiri) ex : bakteri nitrifikasi (bakteri tanah) Padat dicairkan dengan enzim ekstrasel 1.

Faktor Fisik 1. Suhu / Temperatur 2. Pengaruh p. H 3. Pengaruh Kekuatan Ion & Tekanan Osmotik 4. Potensial. Oksida sireduksi (Eh) Faktor – faktor yg mempengaruhi nutrisi Faktor Kimia 1. Air 2. Pengaruh Konsentrasi Oksigen 3. Garam 2 Anorganik 4. Mineral 5. Sumber Nitrogen 6. CO 2 7. Faktor Pertumbuhan

FAKTOR KIMIA 1. Air Kuman memerlukan air dalam konsentrasi tinggi (cukup) disekitarnya karena diperlukan bagi pertumbuhan dan perkembangbiakannya. Air merupakan pengantar semua bahan gizi yang diperlukan sel dan untuk membuang semua zat-zat yang tidak diperlukan. Selain untuk melancarkan reaksi-reaksi metabolik, air juga merupakan bagian terbesar protoplasma. 2. ü Pengaruh Konsentrasi Oksigen Kuman Anaerob Obligat Hidup tanpa O 2, O 2 justru toksis terhadap golongan ini. Kuman Aerob Obligat Tumbuh subur bila ada O 2 dalam jumlah besar. ü

ü Kuman Anaerob Fakultatif mampu tumbuh baik dalam suasana dengan / tanpa O 2. ü Kuman Anaerob Aerotoleran tidak mati dengan adanya O 2 ü Kuman Mikroaerofilik hanya tumbuh baik dalam tekanan O 2 yang rendah.

3. Garam-garam Anorganik diperlukan untuk mempertahankan keadaan koloidal dan tekanan osmotik didalam sel, untuk memelihara keseimbangan asam basa, sebagai bagian dari enzim atau sebagai activator

4. Mineral Ø belerang (sulfur) H 2 S, Sulfat (SO 4) Ø fosfor-fosfat (PO 4) Ø activator enzim : Mg, Fe, K dan Ca. 5. Sumber Nitrogen Sumber nitrogen yang umum dipakai oleh kuman diambil dalam bentuk NO 3, NO 2, NH 3, N 2 dan R-NH 2 (R-radikal organik).

6. CO 2 • Diperlukan dalam proses-proses sintesa. Berdasarkan jenis sumber C yang diperlukan kuman dibagi dalam 2 golongan : • Kuman Autotrof (litotrof) adalah kuman yang hanya memerlukan air, garam inorganik dan CO 2 sebagai sumber C bagi pertumbuhannya (energi yang diperlukan diperoleh dari cahaya atau oksidasi bahan-bahan kimia). - Kuman Autotrof Fotosintetik (Fotolitotrof) memperoleh energi dari cahaya. - Kuman Autotrof Kemosintetik (Kemolitotrof) memperoleh energi dari oksidasi substrat inorganik (Fe, S, NH 3, NO 2 ).

Kuman Heterotrof (Organitrof) adalah kuman yang memerlukan C dalam bentuk senyawa organik (karbohidrat) berupa glukosa untuk pertumbuhannya (semua jenis kuman ini patogen terhadap manusia). Energi yang diperlukan diperoleh dari cahaya atau oksidasi senyawa organik. - Kuman Heterotrof Fotosintetik (Fotoorganotrof) memperoleh energi dari cahaya. - Kuman Heterotrof Kemosintetik (Kemoorganotrof) memperoleh energi dari oksidasi senyawa organik.

7. Faktor Pertumbuhan Banyak kuman heterotrof tidak dapat tumbuh kecuali diberikan faktor-faktor pertumbuhan. Substansi ini dimasukan dalam perbenihan dalam bentuk ekstrak ragi, darah, vitamin B komplek, asam amino, purin dan pirimidin.
